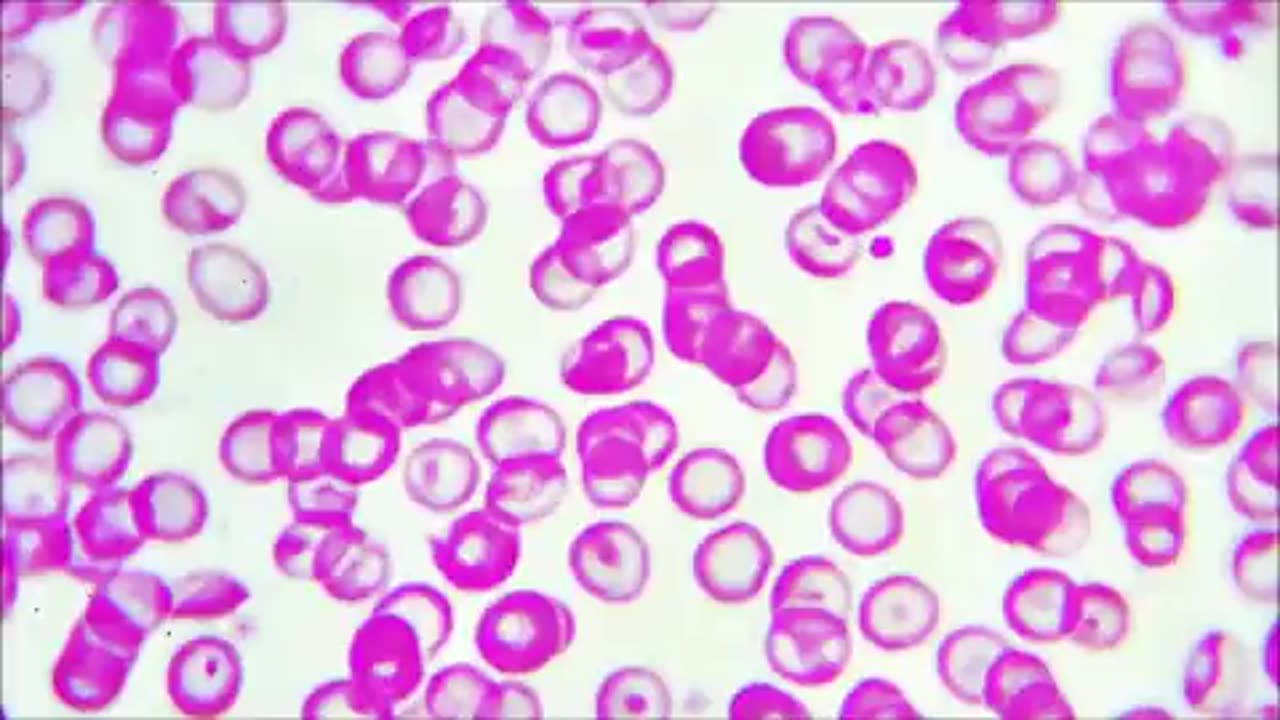

Premium Only Content
This video is only available to Rumble Premium subscribers. Subscribe to
enjoy exclusive content and ad-free viewing.
Autismo - Parasitos
Loading comments...
-
DVR
Michael Franzese
13 hours agoTrump Derangement Syndrome Is On The Way Out | Live with Michael Franzese
46.7K24 -
9:22
Colion Noir
4 hours agoArmed Woman Drags Gunman Out of Store Before Firing Two Shots
43.5K22 -
LIVE
GrimmHollywood
2 hours ago🔴LIVE • GRIMM HOLLYWOOD • ARC RAIDERS • DAY 2 •
128 watching -
LIVE
CassaiyanGaming
2 hours ago🟢LIVE - BATTLEFIELD 6 - MEDIC SHIFT - Doing My Duty
121 watching -
46:10
X22 Report
3 hours agoMr & Mrs X - ICE Is A Threat To The [DS] Agenda, The ICE Insurgency Will Fail - EP 12
70.8K34 -
3:56:47
Shield_PR_Gaming
4 hours ago10/18/25 | WARNING!!! 18+ Battlefield 6 Dev Dogtags?
10.2K1 -
LIVE
Lofi Girl
2 years agoSynthwave Radio 🌌 - beats to chill/game to
125 watching -
LIVE
SilverFox
15 hours ago🔴LIVE - ARC RAIDERS SERVER SLAM TEST! DAY 2!
102 watching -
2:03:11
LFA TV
17 hours agoTHE RUMBLE RUNDOWN LIVE @9AM EST
125K13 -
LIVE
MrR4ger
3 hours agoWERE NOT GAY, WE JUST PLAY ARC RAIDERS W/ TONYGAMING AND AKAGUMO
24 watching